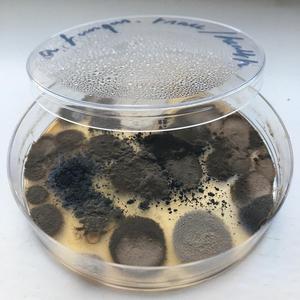
Trace

Trace
DEXCORE

Trace
艾尔肯-Erkin Abdulla

Trace
Harmonia & Eno '76

Travel
T-Chenxi

Traces
Ever So Blue

Traces (396Hz, 417Hz)
En LuCE

Trace
矢鴇つかさ

Trace (Original Mix)
Kyau & Albert

Trace
Tido Kang

TRACE
404martinks

trace
BlackY, Risa Yuzuki

Trace
車谷浩司

Trace
Drik'Sos

TRACE
LOSTMANE

trace
Fennesz, 坂本龍一

Trace
Jeremy Passion

Trace
Ken Arai

Trace
小瀬村晶

Trace
Undrey

Crushing
Trace

Trace
박정현

Trace
Beatsole

떠나간 사람은 오히려 편해
Eddy Kim

trace
Lynu, inci0

TRACE
Ausxlll海川, pamela

trace
菅野よう子

Trace
HOYO-MiX

Trace
小瀬村晶

Trace
Liu Yitao

Trace
汪峰

trace
valetical, inci0

Trace (Original Mix)
Codeko

Trace
Øystein Skar

trace
菅野よう子

Trace
carzpylile, LuHanhann, IVERACITY

trace
兑

TRACE
Russky P, Kateyda

Trace
Re_ii

Trace
V A L E

Trace (Mirror Mix)
V A L E

Trace
Sample M

Trace
Kills Birds

Trace
first.word

Trace
Little Annie

TRACE
SEBA, TCV

Trace
Iaross

Trace
Joseph Kudirka

TRACE
ロケットボーイズ

Trace
LYRA

TRACE
9019

Trace
In All Fairness

Trace
谢康
Trace
a fungus

Trace
Isobel Waller-Bridge, 12 Ensemble

Trace
Row Antic

Trace
Deep Dhaka, Komal Choudhary, Ravinder Khatri